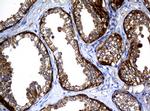
NME1 Antibody in Immunohistochemistry (Paraffin) (IHC (P))
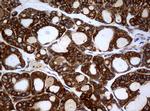
NME1 Antibody in Immunohistochemistry (Paraffin) (IHC (P))

Search
OriGene
NME1 Monoclonal Antibody (OTI3F2), TrueMAB™
{{$productOrderCtrl.translations['antibody.pdp.commerceCard.promotion.promotions']}}
{{$productOrderCtrl.translations['antibody.pdp.commerceCard.promotion.viewpromo']}}
{{$productOrderCtrl.translations['antibody.pdp.commerceCard.promotion.promocode']}}: {{promo.promoCode}} {{promo.promoTitle}} {{promo.promoDescription}}. {{$productOrderCtrl.translations['antibody.pdp.commerceCard.promotion.learnmore']}}
产品信息
TA801258
种属反应
宿主/亚型
分类
类型
克隆号
抗原
偶联物
形式
浓度
纯化类型
保存液
内含物
保存条件
运输条件
靶标信息
NME1 was identified because of its reduced mRNA transcript levels in highly metastatic cells. Nucleoside diphosphate kinase (NDK) exists as a hexamer composed of 'A' (encoded by this gene) and 'B' (encoded by NME2) isoforms. Mutations in the gene have been identified in aggressive neuroblastomas. Two transcript variants encoding different isoforms have been found for this gene. Co-transcription of this gene and the neighboring downstream gene (NME2) generates naturally-occurring transcripts (NME1-NME2), which encodes a fusion protein comprised of sequence sharing identity with each individual gene product.
仅用于科研。不用于诊断过程。未经明确授权不得转售。
篇参考文献 (0)
生物信息学
蛋白别名: GAAD; Granzyme A activated DNase (GAAD); Granzyme A-activated DNase; GZMA activated DNase; included; Metastasis inhibition factor nm23; NDK A; NDP kinase A; NM23-H1; NM23H1B; NME1-NME2 spliced read-through transcript; non-metastatic cells 1, protein (NM23A) expressed in; Nucleoside diphosphate kinase A; Tumor metastatic process-associated protein
基因别名: AWD; GAAD; NB; NBS; NDKA; NDPK-A; NDPKA; NM23; NM23-H1; NME1
UniProt ID: (Human) P15531
Entrez Gene ID: (Human) 4830